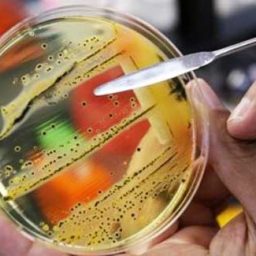
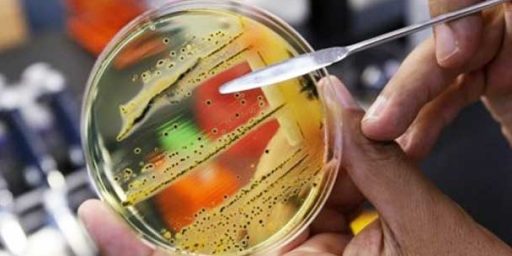

Taxing The Rich Won’t Alleviate Income Inequality
Increasing taxes on the rich may be a fiscal policy worth talking about, but it won’t make the poor richer.


Increasing taxes on the rich may be a fiscal policy worth talking about, but it won’t make the poor richer.


European leaders continue to kick the can down the road on a crisis that could bring down the global economy.


With the advantage of hindsight, it’s clear that more creative strategies were needed. But they probably couldn’t have been passed.


It’s time to start being concerned about Europe.
A meme is emerging that the Occupy Wall Street protests are America’s version of the Arab Awakening. That meme must die.


A mustachioed German has once again sent the world into panic. This time, it involves euros not tanks.


Lost in the hubbub of S&P downgrading the US bond rating is news that the Italian government has the ratings agencies under criminal investigation.
European leaders have put another Band Aid on the Greek sovereign debt crisis while America’s leaders are trying to stave off a self-inflicted financial default.


I’m continually shocked when demonstrably bright and accomplished people fall in love with authoritarian states.
More on the attack at Moscow’s Domodedovo airport.


Do republics expire after 200 years due to fiscal irresponsibility?


The long awaited new strategic concept, launching what has been termed “NATO 3.0,” has been published under the banner “Active Engagement, Modern Defense.”


Terrorism risk assessment: Russia at “Extreme Risk”, Greece at “High Risk”, U. S. at “Medium Risk”, Canada and Germany at “Low Risk”.


Once again, Angela Merkel has held her ground and forced the other EU leaders to accommodate Germany’s policy concerns. This time, it’s a set of amendments to the Lisbon Treaty to deal with sovereign debt emergencies.


What do the critics mean when they say that the United States should be more like Germany?

Mutated bacteria spreading in India could mark the end of effective antibiotic drugs. The medical repercussions would be enormous.


Twenty-five years after retiring as President Reagan’s Budget Director, David Stockman is back with a scathing indictment of Republican fiscal policies over the past four decades.


President Obama’s powers of persuasion were severely lacking at the G-20 Summit this weekend.